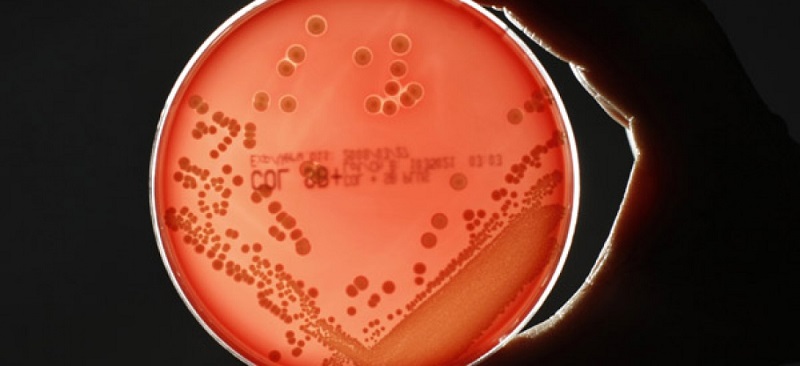

Modulation de fréquence pour la prévention efficace
Intervenir sur l’écosystème intestinal pour soigner jusqu’aux maladies… mentales
Un organe en construction dès la naissance
Stratégies d’innovation et bioéthique
Montre moi ton microbiote et je te dirai comment tu vas








